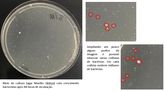

O uso correto é capaz de dificultar a propagação de doenças transmitidas por secreções respiratórias, como o coronavírus
Nos últimos meses o uso de máscara se tornou cada vez mais frequente, em virtude da pandemia da Covid-19. Um estudo feito pelo curso de Farmácia da Universidade Paranaense - Unipar, Unidade de Francisco Beltrão, comprovou a importância do uso das máscaras para evitar a contaminação pelo coronavírus e/ou outras doenças transmitidas por meio de secreções respiratórias.
A pesquisa, utilizando uma máscara cirúrgica descartável, foi feita em diferentes etapas, sempre em laboratório. No primeiro teste, a modelo tossiu várias vezes em direção à placa contendo um meio de cultura. Após 48 horas na estufa bacteriológica nenhum microrganismo cresceu. Na lâmina, observa-se somente algumas bolhas no meio de cultura, que já existiam antes do experimento.
Na segunda parte do teste, a modelo não utilizou a máscara, ela tossiu em direção a uma outra placa com meio de cultura. Após 48 horas na estufa bacteriológica o resultado observado foi bem diferente do anterior [em que ela utilizou a máscara]: várias colônias de bactérias cresceram, mostrando que as secreções respiratórias atingiram o meio de cultura e carregaram com elas os microrganismos presentes.
Segundo a professora Patrícia Amaral Gurgel Velasquez, coordenadora do curso de Farmácia, caso a placa fosse uma pessoa, uma superfície ou o próprio ar ambiente, a máscara possibilitaria proteção de contaminação pelas secreções expelidas durante a tosse.
“No teste não é possível demonstrar o crescimento de vírus, pois estes precisam de células humanas para crescer, mas o fato de bactérias presentes na saliva terem crescido, mostra que outros patógenos podem ser transmitidos desta forma”, comenta Patrícia.
O objetivo do estudo é mostrar que a máscara quando utilizada, de maneira correta, pode evitar a propagação de doenças transmitidas por secreções respiratórias [mesmo que a pessoa esteja sem sintomas] como o sarampo, a tuberculose, a gripe comum e a Covid-19.